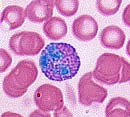
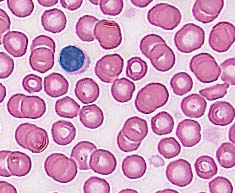
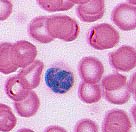
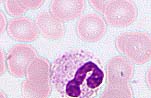
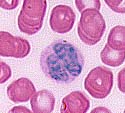
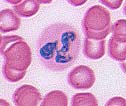
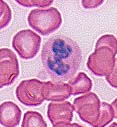

lymph node


thymus

bone marrow


blood cells



Examples of Lymphocytes
Antibodies
Antibody-mediated
(humoral) immunity is regulated by B cells and the antibodies they
produce. Cell-mediated immunity is controlled by T cells.
Antibody-mediated reactions defend against invading viruses and
bacteria. Cell-mediated immunity concerns cells in the body that have
been infected by viruses and bacteria, protect against parasites, fungi,
and protozoans, and also kill cancerous body cells.
Antibody-mediated Immunity
Stages in this process are:
- antigen detection
- activation of helper T cells
- antibody production by B cells
Macrophages
are
white blood cells that continually search for foreign (nonself)
antigenic molecules, viruses, or microbes. When found, the macrophages
engulfs and destroys them. Small fragments of the antigen are displayed
on the outer surface of the macrophage plasma membrane.
Antibodies
bind to specific antigens in a lock-and-key fashion, forming an
antigen-antibody complex. Antibodies are a type of protein molecule
known as immunoglobulins. There are five classes of immunoglobulins:
IgG, IgA, IgD, IgE, and IgM
A
unique antigenic determinant recognizes and binds to a site on the
antigen, leading to the destruction of the antigen in several ways. The
ends of the Y are the antigen-combining site that is different for each
antigen.
Helper
T cells activate B cells that produce antibodies. Supressor T cells
slow down and stop the immune response of B and T cells, serving as an
off switch for the immune system. Cytotoxic (or killer) T cells destroy
body cells infected with a virus or bacteria. Memory T cells remain in
the body awaiting the reintroduction of the antigen.
A
cell infected with a virus will display viral antigens on its plasma
membrane. Killer T cells recognize the viral antigens and attach to that
cell's plasma membrane. The T cells secrete proteins that punch holes
in the infected cell's plasma membrane. The infected cell's cytoplasm
leaks out, the cell dies, and is removed by phagocytes. Killer T cells
may also bind to cells of transplanted organs.
The
immune system is the major component of this defense. Lymphocytes,
monocytes, lymph organs, and lymph vessels make up the system. The
immune system is able to distinguish self from non-self. Antigens are
chemicals on the surface of a cell. All cells have these. The immune
system checks cells and identifies them as "self" or "non-self".
Antibodies are proteins produced by certain lymphocytes in response to a
specific antigen. B-lymphocytes and T-lymphocytes produce the
antibodies. B-lymphocytes become plasma cells which then generate
antibodies. T-lymphocytes attack cells which bear antigens they
recognize. They also mediate the immune response.
Success of organ transplants and skin grafts requires a matching of
histocompatibility antigens that occur on all cells in the body.
Chromosome 6 contains a cluster of genes known as the human leukocyte
antigen complex (HLA) that are critical to the outcome of such
procedures. The array of HLA alleles on either copy of our chromosome 6
is known as a haplotype.
The
large number of alleles involved mean no two individuals, even in a
family, will have the same identical haplotype. Identical twins have a
100% HLA match. The best matches are going to occur within a family. The
preference order for transplants is identical twin > sibling >
parent > unrelated donor. Chances of an unrelated donor matching the
recipient range between 1 in 100,000-200,000. Matches across racial or
ethnic lines are often more difficult. When HLA types are matched
survival of transplanted organs dramatically increases.
Antigens
Antigen Matching

0 التعليقات:
Post a Comment